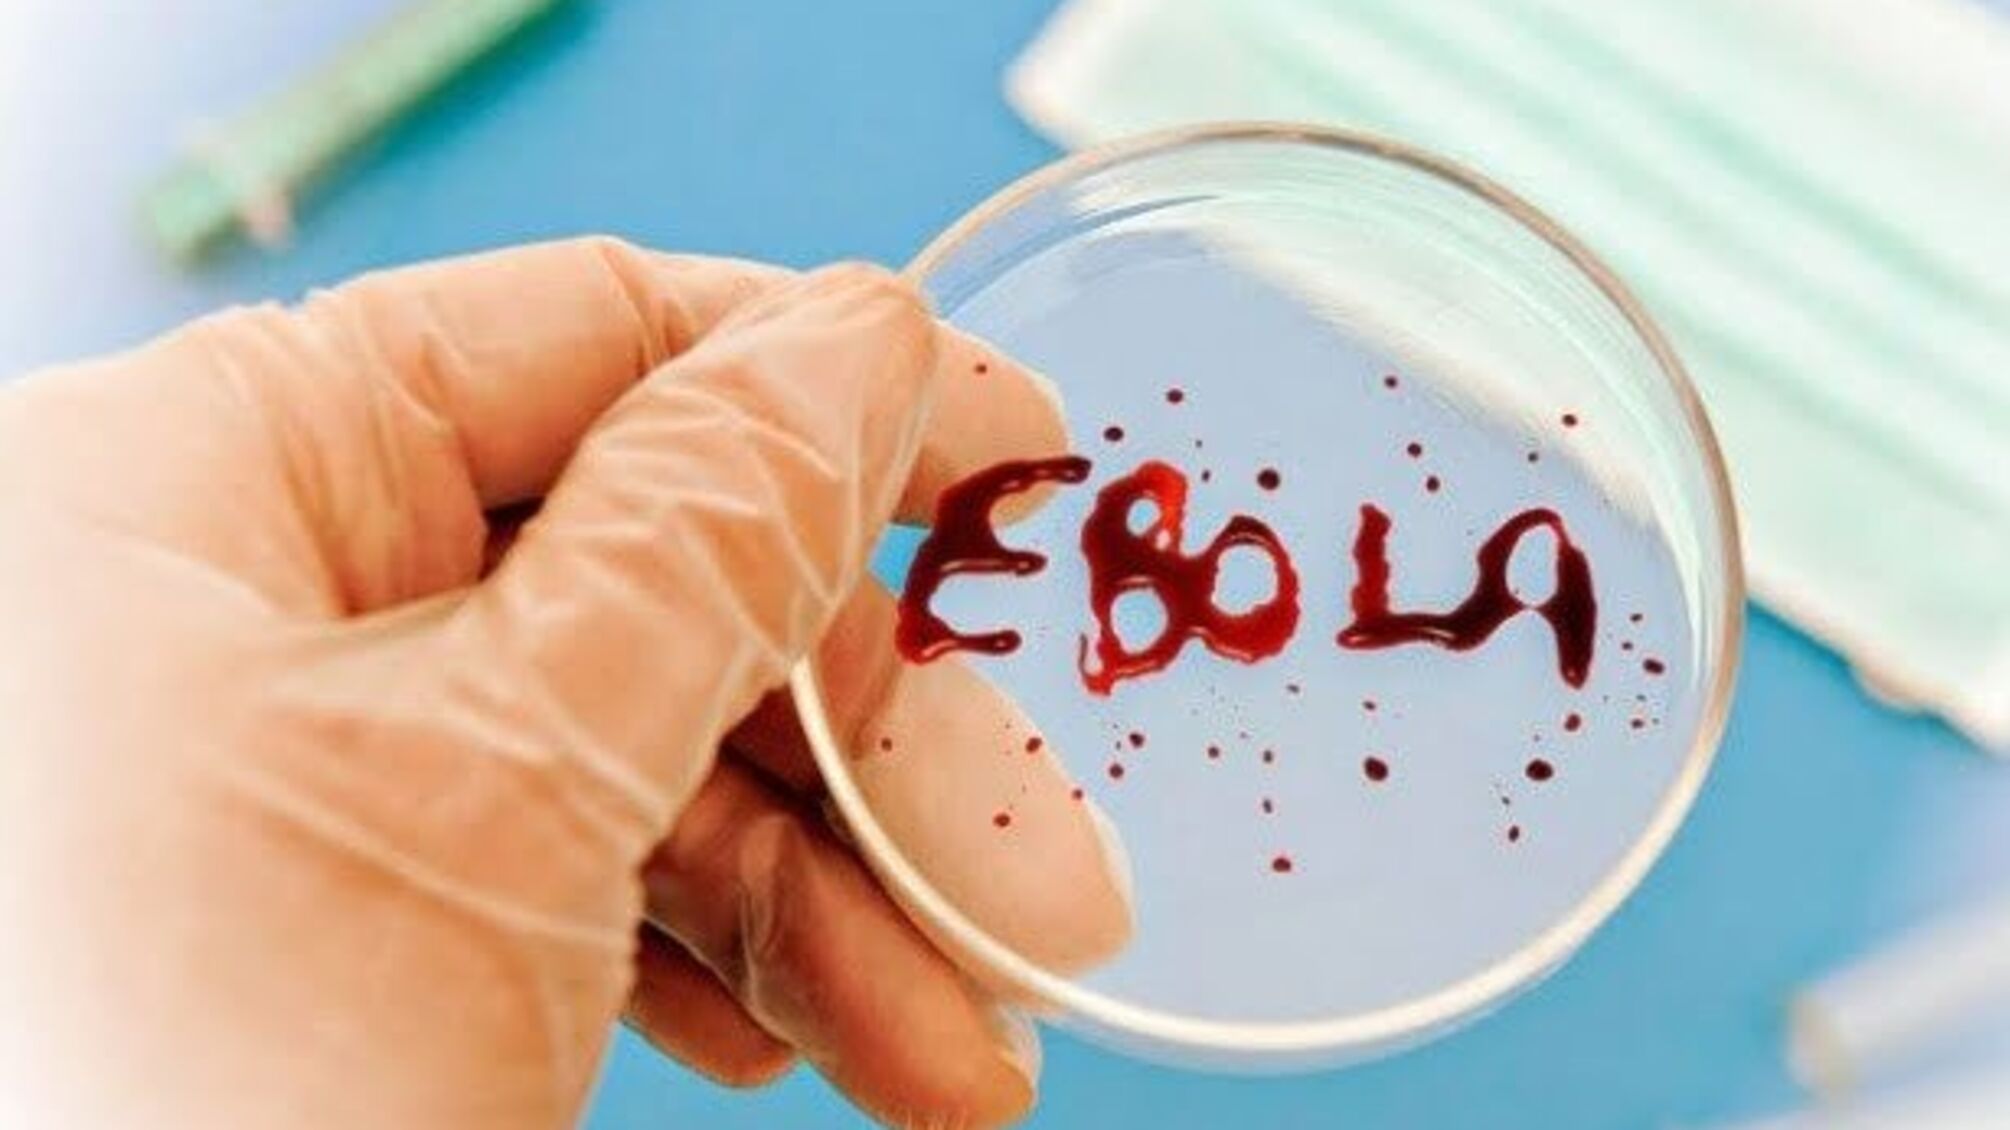
У Конго знову зафіксували смерть від Еболи

Про це повідомляє пресслужба ВООЗ, передає Укрінформ.
Міністерство охорони здоров'я Демократичної Республіки Конго заявило про смерть жінки від вірусу Ебола у місті Бутембо в провінції Північне Ківу, яке було одним із епіцентрів попереднього спалаху хвороби у червні 2020 року.
Вона звернулася до лікарні з симптомами подібними до Еболи. Зазначається, що пацієнтка була дружиною чоловіка, що переніс хворобу під час попереднього спалаху. Жінку не змогли врятувати. Аналізи підтвердили, що причиною смерті стала Ебола.
«ВООЗ надає підтримку місцевим та національним органам охорони здоров’я для швидкого відстеження, ідентифікації та лікування контактних осіб, щоб стримати подальше поширення вірусу», — заявив регіональний директор ВООЗ Матшідісо Моеті.
Команда епідеміологів ВООЗ працює на місці. Вже виявлено понад 70 контактів. Також триває дезінфекція місць, які відвідує пацієнт.
Десятий спалах Еболи, що тривав майже два роки, був другим за величиною у світі, і на момент його закінчення було зареєстровано 3481 випадок, 2299 людей померли.
Після спалаху ВООЗ створило резерви вакцини від вірусу Ебола на випадок термінового реагування.
Джерело: Укрінформ






